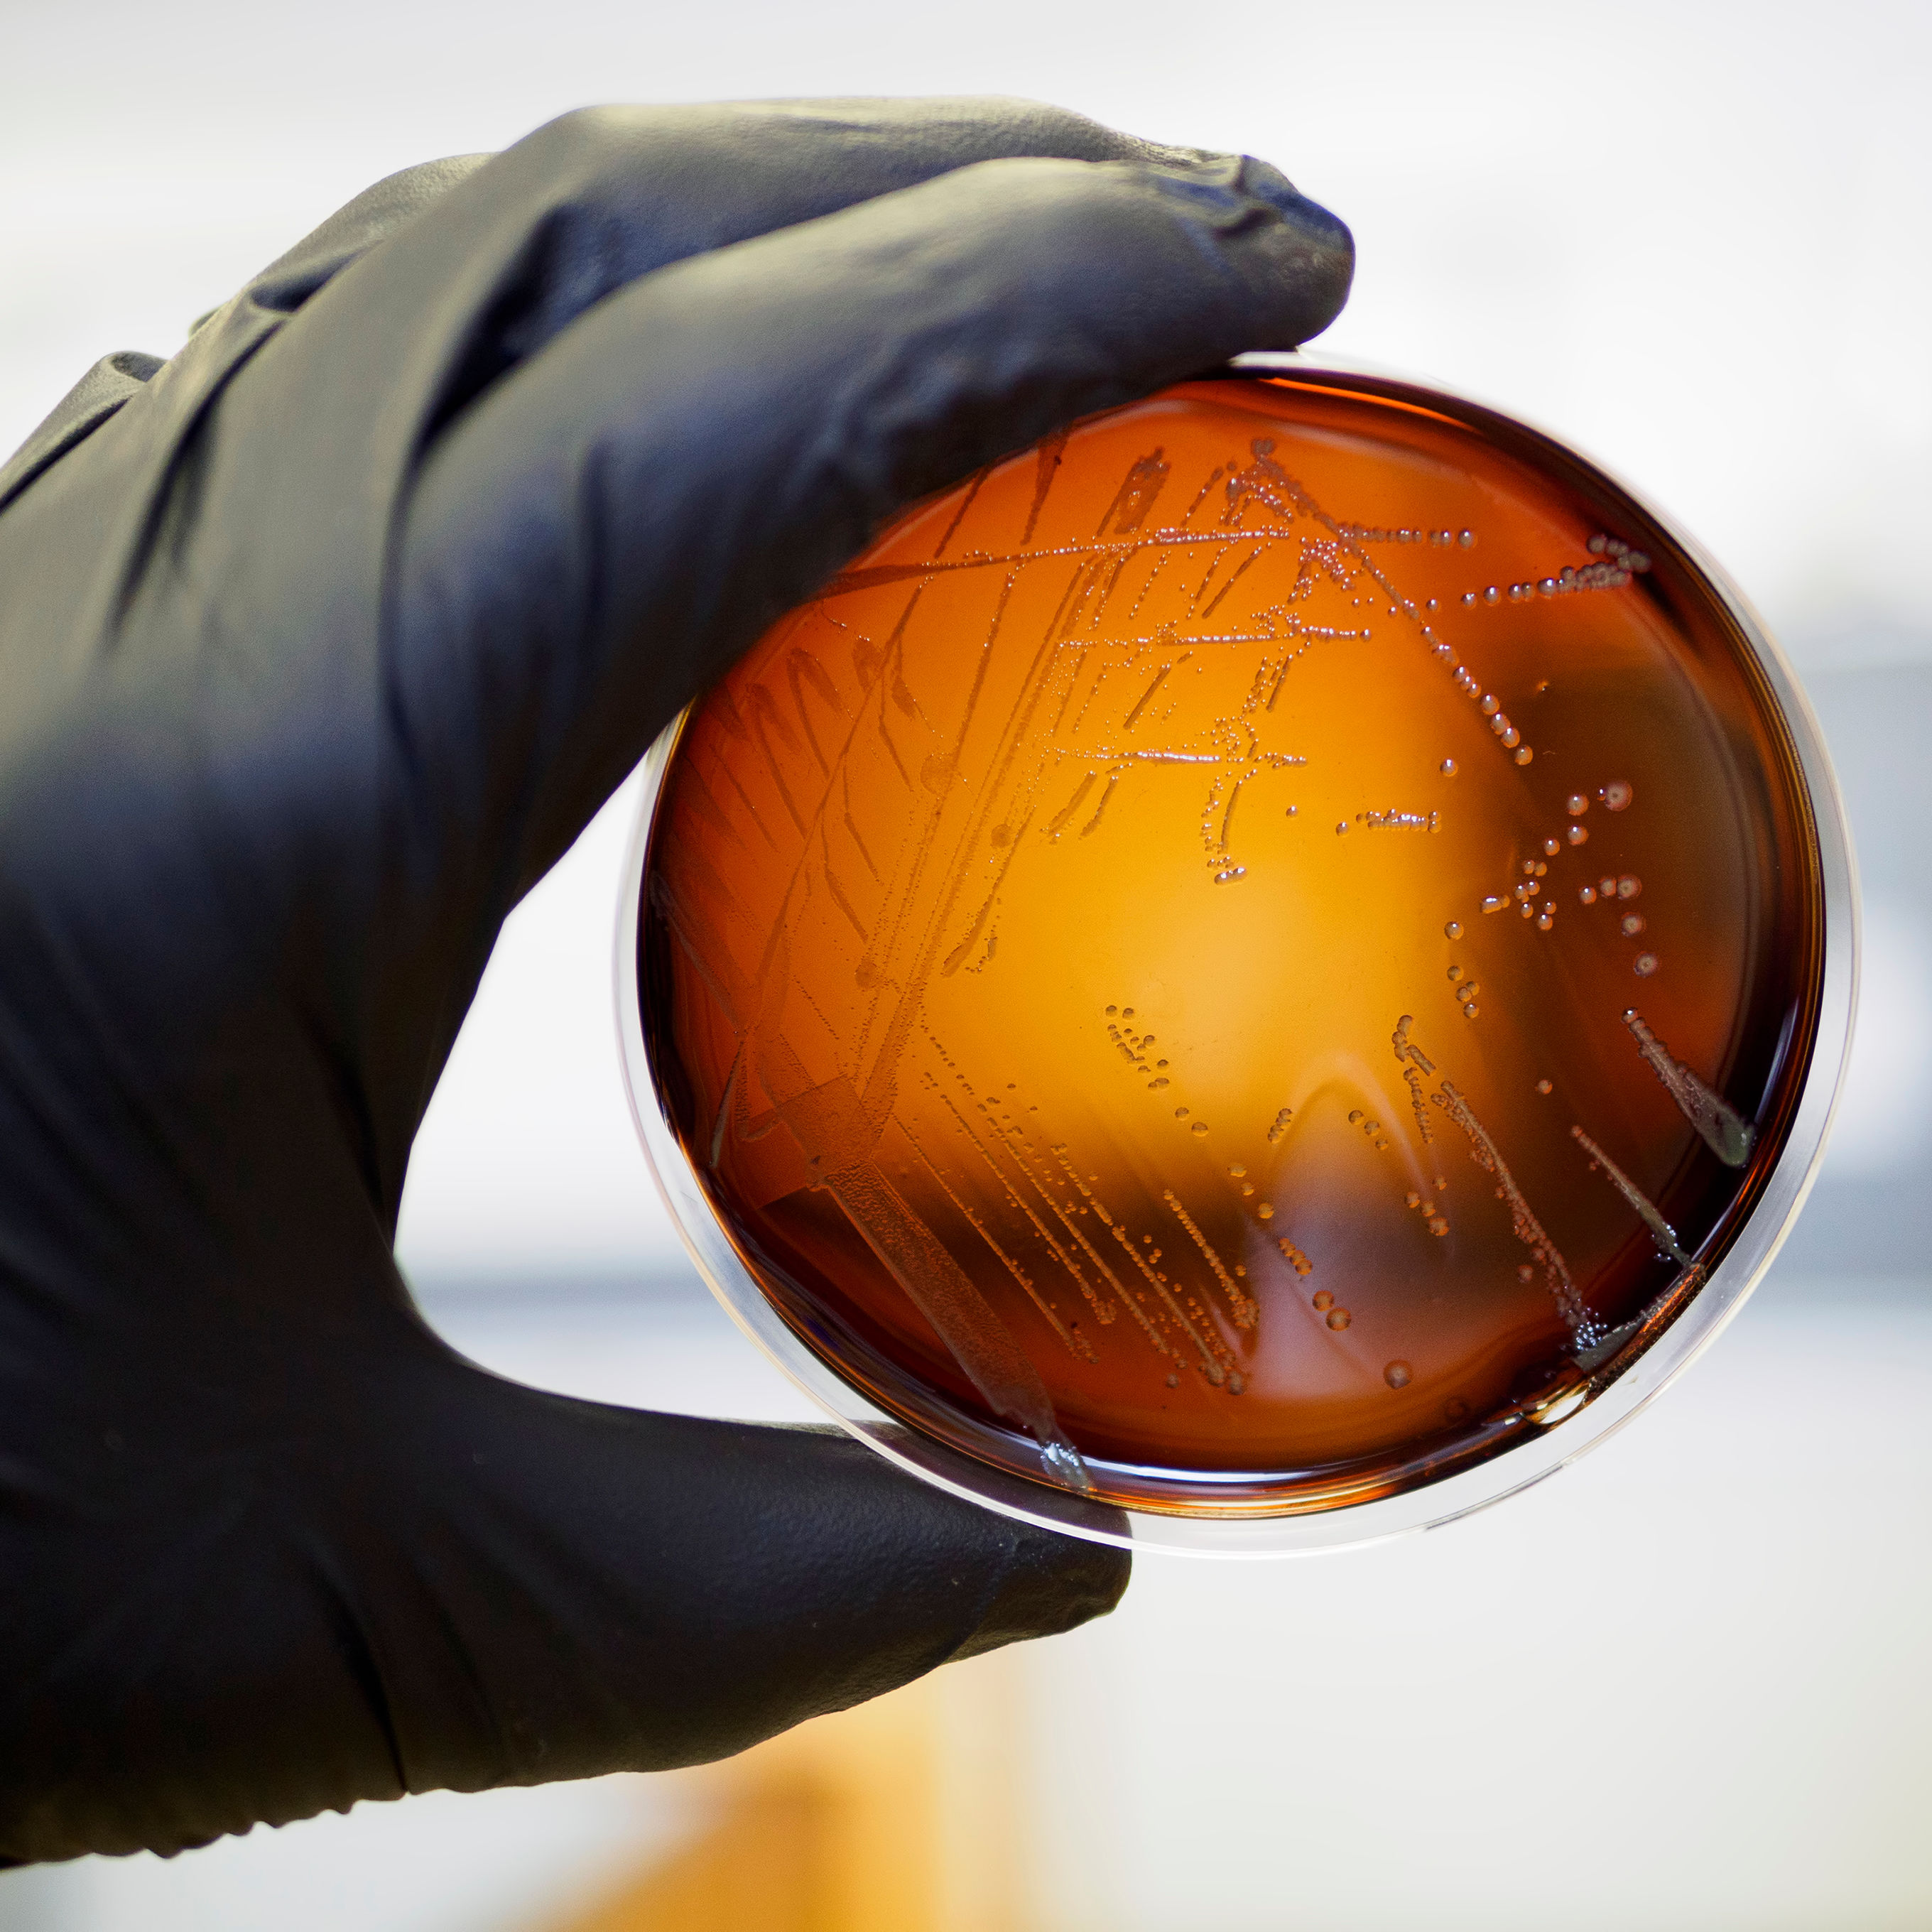

Producer
Cooper Levey-Baker
Senior Editor, Food Editor Email

Cooper Levey-Baker has written about food, politics, civic issues, the arts, and music in Southwest Florida for 15 years. His work has won multiple awards from the Florida Magazine Association and the Florida Society of Professional Journalists, as well as an honorable mention from the Julia Child Foundation. Follow him on Twitter: @LeveyBaker.

From the Editor
The Freedom to Read

Top 10 in 2022
10 Great Reads From a Year Full of Them

Welcome to Scare-Asota
Five Sarasota-Set Horror Movies We'd Like to See Get Made Tomorrow

Just in Time for Halloween
Our Favorite Stephen King TV and Movie Adaptations

Shopping list
How to Find What's in Season in Florida

Neighborhood Guide
The Best Restaurants on Siesta Key

Pumpkin Mindset
Pumpkin Spice Season Is Back, Baby

Believe the Hype
Meliora Is One of Sarasota's Best New Restaurants

Local Favorites
The Best Restaurants in Gulf Gate

Neighborhood Guide